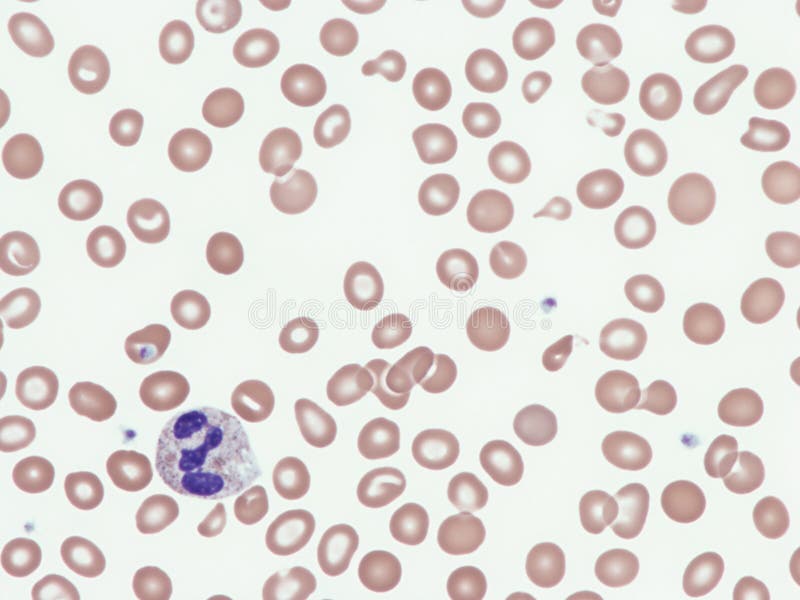
alfa talasemia que es

L’Alpha-Thalassémie : Comprendre cette Maladie Génétique
L’alpha-thalassémie est une maladie génétique rare qui affecte la production d’hémoglobine, une protéine essentielle des globules rouges. Cette condition héréditaire est caractérisée par une déficience en chaînes alpha de l’hémoglobine, ce qui entraîne une anémie et d’autres complications chez les personnes atteintes.
Causes de l’Alpha-Thalassémie
L’alpha-thalassémie est causée par des mutations génétiques qui affectent les gènes responsables de la production des chaînes alpha de l’hémoglobine. Ces mutations peuvent être transmises par les parents aux enfants, augmentant ainsi le risque pour la progéniture de développer la maladie.
Symptômes et Complications
Les symptômes de l’alpha-thalassémie varient en fonction du type et de la gravité de la maladie. Les personnes atteintes peuvent présenter une anémie légère à sévère, une fatigue chronique, une pâleur de la peau, des problèmes cardiaques et hépatiques, ainsi que des retards de croissance chez les enfants.
Diagnostic et Traitement
Le diagnostic de l’alpha-thalassémie repose sur des tests sanguins spécifiques pour évaluer le taux d’hémoglobine et identifier les mutations génétiques associées à la maladie. Le traitement vise à soulager les symptômes et à gérer les complications, notamment par des transfusions sanguines régulières, des suppléments en fer et parfois une greffe de moelle osseuse chez certains patients.
Prévention et Suivi Médical
Il est essentiel pour les personnes atteintes d’alpha-thalassémie de bénéficier d’un suivi médical régulier pour surveiller leur état de santé, ajuster le traitement si nécessaire et prévenir les complications potentielles. La consultation génétique peut également aider les familles à comprendre le risque de transmission de la maladie aux générations futures.
Dans l’ensemble, bien que l’alpha-thalassémie puisse poser des défis au quotidien pour ceux qui en souffrent, une prise en charge adéquate peut contribuer à améliorer leur qualité de vie et réduire le fardeau associé à cette condition génétique complexe.
6 Conseils Essentiels pour Comprendre et Gérer l’Alpha-Thalassémie
- L’alpha-thalassémie est une maladie du sang héréditaire.
- Elle affecte la production de globules rouges.
- Les symptômes peuvent varier en fonction de la gravité de la maladie.
- Le dépistage génétique peut aider à identifier les porteurs sains et les personnes à risque.
- Un suivi médical régulier est essentiel pour gérer l’alpha-thalassémie.
- Il est important de consulter un spécialiste pour un traitement approprié.
L’alpha-thalassémie est une maladie du sang héréditaire.
L’alpha-thalassémie est une maladie du sang héréditaire qui affecte la production des chaînes alpha de l’hémoglobine, une protéine essentielle des globules rouges. Cette condition génétique peut être transmise des parents aux enfants et se caractérise par une déficience en chaînes alpha, entraînant divers symptômes tels qu’une anémie et d’autres complications chez les personnes touchées.
Elle affecte la production de globules rouges.
L’alpha-thalassémie est une condition génétique qui perturbe la production de globules rouges, les cellules sanguines essentielles responsables du transport de l’oxygène dans tout le corps. Cette altération dans la production des globules rouges peut entraîner une anémie et d’autres complications chez les individus atteints de cette maladie héréditaire.
Les symptômes peuvent varier en fonction de la gravité de la maladie.
Les symptômes de l’alpha-thalassémie peuvent varier considérablement en fonction de la gravité de la maladie. Des manifestations légères telles qu’une fatigue persistante et une pâleur de la peau peuvent être observées chez certains patients, tandis que d’autres peuvent présenter des symptômes plus graves tels qu’une anémie sévère, des problèmes cardiaques et hépatiques. Il est donc essentiel de consulter un professionnel de la santé pour un diagnostic précis et un traitement adapté en fonction du profil individuel du patient.
Le dépistage génétique peut aider à identifier les porteurs sains et les personnes à risque.
Le dépistage génétique est un outil essentiel pour identifier les porteurs sains de l’alpha-thalassémie et les personnes à risque de développer la maladie. En permettant une détection précoce des mutations génétiques associées à l’alpha-thalassémie, le dépistage peut aider à orienter les décisions en matière de planification familiale et de suivi médical. Grâce à cette approche proactive, il est possible d’offrir un soutien approprié aux individus concernés et de mettre en place des mesures préventives pour réduire l’impact de la maladie sur leur santé et celle de leur descendance.
Un suivi médical régulier est essentiel pour gérer l’alpha-thalassémie.
Un suivi médical régulier est indispensable pour la gestion efficace de l’alpha-thalassémie. Grâce à des consultations médicales fréquentes, les patients atteints de cette maladie génétique peuvent bénéficier d’un suivi attentif de leur état de santé, ajuster leur traitement en fonction de l’évolution de la maladie et prévenir d’éventuelles complications. Ce suivi médical permet également aux professionnels de santé d’offrir un soutien continu aux patients et à leur famille, contribuant ainsi à améliorer leur qualité de vie malgré les défis posés par l’alpha-thalassémie.
Il est important de consulter un spécialiste pour un traitement approprié.
Il est crucial de consulter un spécialiste pour bénéficier d’un traitement adapté en cas d’alpha-thalassémie. Seul un médecin spécialisé dans cette maladie génétique pourra évaluer correctement la situation, prescrire les traitements nécessaires et assurer un suivi médical approprié pour améliorer la qualité de vie des patients concernés.